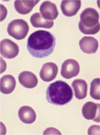
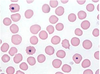

Histology Flashcards

Basophil
- 12 um
- 2 lobes can’t be seen bc of large purple-black granules
- “Related” to mast cells
- involved in hypersensitivity/allergic response
- Production induced by IL-3 (Mast cells are by SCF)

Eosinophil
- 12-17 um
- Large Orange-Red Granules
- 1-4 lobes (most have 2)
- Chronic inflammatory response
- Infection defense: parasites/fungi
- Phagocytosis capability (but minimal)
Lymphocyte
- 7-12 um; most are small unless reactive
- Large round/indented nucleus
- Blueish cytoplasm
- T, B, NK cells

Monocyte
- 15-30 um
- Large kidney/lobulated nucleus
- fine granules
=> Macrophages in tissues
- Chronic inflammatory response
- Some native within tissue: sentinel cells
- Phagocytize / neutralize / degrade
injurious agents - Regulate inflammatory / immune response

Neutrophil
- 9-15 um
- 2-5 lobes
- fine granules
- cytoplasm acidophilic
- Acute inflammatory response
- Phagocytose: bacteria, tissue debris
- Damage bugs (and tissue)
- Production stim by IL-5

Platelet
- 2-3 um
- irregular outline
- light blue cytoplasm
- many fine azurphilic granules

Bite Cells
- From Heinz bodies removed in spleen
- Assoc w/ G6PD def

Target Cells
-Thalassemia, hemoglobin C, iron deficiency, liver disease
Bottom L & Middle R

Hypersegmented Neutrophil
- >5 lobes
- Assoc w/ megaloblastic anemia

Toxic Granulation
Due to rapid cell division (not enough time to dilute)
Often associated with Döhle bodies and toxic vacuolization
Causes: bacterial infection, marrow recovery, G(M)-CSF

Dohle Body
Pale blue inclusion at the periphery of the cytoplasm
Infection, inflammation, burns or pregnancy
Contents: condensed RNA.

Heinz Body
Need to stain with supravital dye (crystal violet)
Denatured/oxidized hemoglobin attached to the inner cell membrane
Cause: G6PD deficiency
Associated with bite cells
Howell-Jolly bodies
Morphology: single, dense, blue dot
Content: nuclear DNA remnant
Causes:
Post-splenectomy
Functional asplenia
Megaloblastic anemia
Myelodysplasia

Sickle Cell
Bipolar spiculated shape or banana shape
Hb SS


